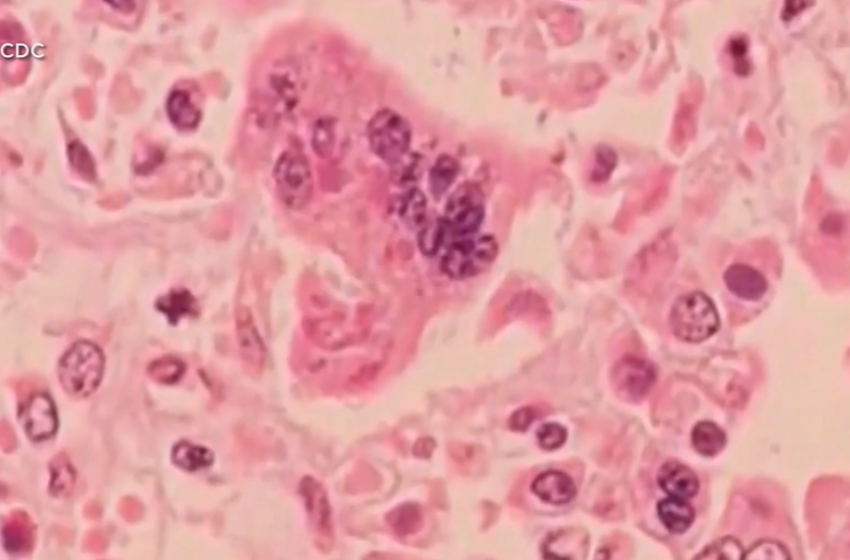
Over 50 cases of measles confirmed at Ave Maria University – WINK News

Over 50 cases of measles confirmed at Ave Maria University – WINK News
- Over 50 cases of measles confirmed at Ave Maria University WINK News
- Measles is spreading across Florida. The state’s updates lag more than a week WUSF
- Campus measles outbreak grows in Florida CIDRAP
- Measles outbreak in Florida sparks concern from Central Florida doctors WFTV
- Is there a measles outbreak in Florida? Where the cases are Naples Daily News
First Appeared on
Source link






